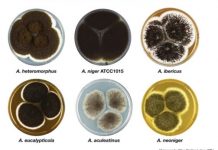
Research: Researchers build a genetic profile for a section of Aspergillus fungi —

Research: Genomic analysis helps in discovery of unusual new bird species from Indonesia —
A joint research team from the National University of Singapore (NUS) and Indonesian Institute of Science has described an unusual new songbird species....
Research: Harmful pesticides lurking in New York State homes —
Despite the existence of chemical-free methods to eradicate pests, Americans use more than a billion pounds of pesticides per year. These chemicals are...
Research: Ultra-close stars discovered inside a planetary nebula —
An international team of astronomers have discovered two stars in a binary pair that complete an orbit around each other in a little...
Research: Mineral discoveries in the Galapagos Islands pose a puzzle as to their formation...
The Galapagos archipelago is one of the most famous groups of islands in the world. Many of the animal and plant species are...
Research: For a lower climate footprint, vegetarian diet beats local —
A new study provides a more comprehensive accounting of the greenhouse gas emissions from EU diets. It shows that meat and dairy products...
Research: Changes in snow coverage threatens biodiversity of Arctic nature —
Many of the plants inhabiting northern mountains depend on the snow cover lingering until late spring or summer. Snow provides shelter for plants...
Research: Bonobos make themselves appear ‘smaller’ than they actually are —
Although bonobos and chimpanzees are similar in...
Research: Fish give up the fight after coral bleaching —
Researchers found that when water temperatures heat up for corals, fish 'tempers' cool down, providing the first clear evidence of coral bleaching serving...
Research: Huge motor complex imports proteins into chloroplasts —
Over 1 billion years ago, a relationship began between the ancestor of all living plants and a type of bacterium that paved the...
Research: Researchers build a genetic profile for a section of Aspergillus fungi —
There are millions of fungal species, and those few hundred found in the Aspergillus genus play important roles in areas ranging from industrial...
Top News
Hey ISIS, You Suck: Local Muslims Post Anti-ISIS Billboard
A new billboard on Manchester Road in Missouri reads, "HEY ISIS, YOU SUCK!!! From: #ActualMuslims."
A group of Muslim-Americans have put up a blunt billboard...